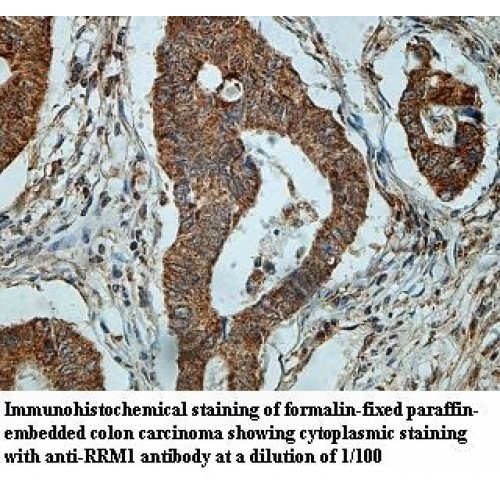
RRM1 Antibody

Cart 0 Product Products (empty)
No products
Free shipping! Shipping
$0.00 Total
Product successfully added to your shopping cart
Quantity
Unit
Total
There are 0 items in your cart. There is 1 item in your cart.
Total products (tax excl.)
Total shipping (tax excl.) Free shipping!
Total (tax excl.)
Antibodies and Kits
- Protein Control Ligand
- Pathway Inhibitors
- Enzyme Inhibitors
- Kinase Inhibitors
- Protease
- Synthase
- p18
- p38
- p53
- p70
- p90
- Peptidase
- Carboxyl and Decarboxylases
- Ceramide Turnover Enzymes
- Chromatin Modifying Enzymes
- Cyclic Nucleotide Turnover Enzymes
- Glycerophospholipid Turnover Enzymes
- Hydroxylases
- Ubiquitin-Activating Enzyme
- Adenosine Deaminase
- Clathrin
- Nuclease
- p68
- ACE
- COX
- DHFR
- Neprilysin
- NF-κB
- RAF
- RAS
- Reductase
- ROR
- Topoisomerase
- Transferase
- Protein Inhibitors
- Transporter Inhibitors
- Cell Inhibition
- Synthase
- Receptor Tyrosine Phosphatases (RTP)
- AChE
- Peptidase
- Autophagy
- Toll-Like Receptor (TLR)
- Enzyme Inhibitors
- Function Modulators
- Activators
- G Protein-Coupled Receptor Ligands
- 5HT Receptors
- Adrenoceptor
- Angiotensin Receptor
- Cannabinoid Receptors
- CCK Receptors
- DA Receptors
- EAA Receptors
- Ghrelin Receptors
- GABA Receptors
- Histamine Receptors
- Leukotriene Receptors
- Metabotropic Glutamate Receptors
- Motilin Receptors
- Muscarinic Receptor
- Neuropeptide Receptors
- Opioid Receptors
- Orexin Receptors
- Orphan Receptors
- Prostanoid Receptors
- Proteinase-Activated Receptors
- Purinergic Receptors
- Ryanodine receptor
- Sigma Receptors
- Thrombin Receptor
- Vaniloid Receptor
- VIP and PACAP Receptors
- Neurotensin Receptors
- Urotensin Receptor
- Imidazoline receptor
- SMO Receptors
- Apelin Receptor
- β-arrestin/β2-adaptin
- KDM4
- Glucocorticoid Receptor
- Laminin Receptor
- AHR
- Amylin Receptor
- Bombesin Receptor
- Bradykinin Receptor
- CFTR
- CGRP Receptor
- CRFR
- Endothelin Receptor
- Ephrin Receptor
- Farnesoid X receptor (FXR)
- Glucagon Receptor
- Nuclear Receptor Ligands
- GDNF Receptors
- TNF Receptors
- Transcription Factors
- Chemokines
- Cytokine Receptors
- Biomarkers and Buffer Solutions
- Molecular Probes
- Stem Cell Research
- Alzheimer's Disease
- Apoptosis
- Cancer Research
- Epigenetics
- Metabolites
- PET/SPECT Imaging Precursors
- Customized Screening Library
- Ultra Pure Pharmacological Standard
- Tissue Microarray (TMA)
- Proteins and Antibodies
- Primary Cells
- ELISA KIT
- Natural Products
- Lab Equipments
- Humanized Mice for PDX Platform
- Rare Chemicals
- Custom Synthesis
- Antibacterial
- Antifungal
- Antioxidant
- Antiviral
- Molecular Glues
- PROTAC Linker
- SARS-CoV
RRM1 Antibody
NCTP08096
Description: Rabbit polyclonal to human RRM1
Application: ELISA, WB, IHC
Reactivity: Human
Catalog #: NCTP08096
$380.00
1000 Items
Molarity Calculation Cart®
HOW TO ORDER
More info
| DESCRIPTION | |
| Species Reactivity | Human. Predicted reacts with rat, mouse. Other species not tested. |
| Isotype | IgG |
| Immunogen | Recombinant human RRM1 protein 532-745aa |
| Accession # | P23921 |
| Alternative Names | Ribonucleoside-diphosphate reductase large subunit, Ribonucleoside-diphosphate reductase subunit M1, Ribonucleotide reductase large subunit, RR1 |
| Purification | Purified by protein affinity column. |
| Formulation | Lyophilized with 1% BSA and 0.02% NaN3. |
| Size | 100µg/200µl |
| APPLICATION | |
| ELISA | 1:20,000-1:80,000 |
| Western Blot | 1:200-1:1,000 |
| Immunohistochemistry | 1:100-1:500 |
| - | For research use only. Optimal dilutions/concentrations should be determined by each laboratory for each application. |
| PREPARATION AND STORAGE | |
| Reconstitution | Reconstitute in 200µl of sterile H2O. |
| Storage | Shipped at ambient temperature. Store immediately at -20°C upon receipt. Avoid repeated freeze-thaw cycles. |
| REFERENCES | |
| - | Lee SY, Im SA, Park YH et al. Genetic polymorphisms of SLC28A3, SLC29A1 and RRM1 predict clinical outcome in patients with metastatic breast cancer receiving gemcitabine plus paclitaxel chemotherapy. Eur. J. Cancer 50 (4), 698-705 (2014). |